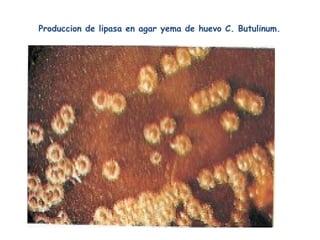
Produccion de lipasa en agar yema de huevo C. Butulinum.
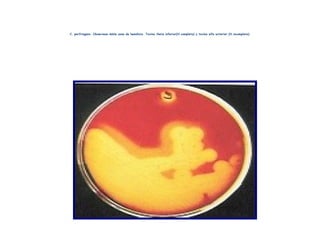
C. perfringens. Observese doble zona de hemólisis. Toxina theta inferior(H.completa) y toxina alfa exterior (H.incompleta)

Las clostridias son bacterias anaerobias grampositivas formadoras de esporas. Algunas especies son patógenas y causan enfermedades como el tétanos (Clostridium tetani), el botulismo (Clostridium botulinum), la colitis pseudomembranosa (Clostridium difficile) y la gangrena gaseosa (Clostridium perfringens).